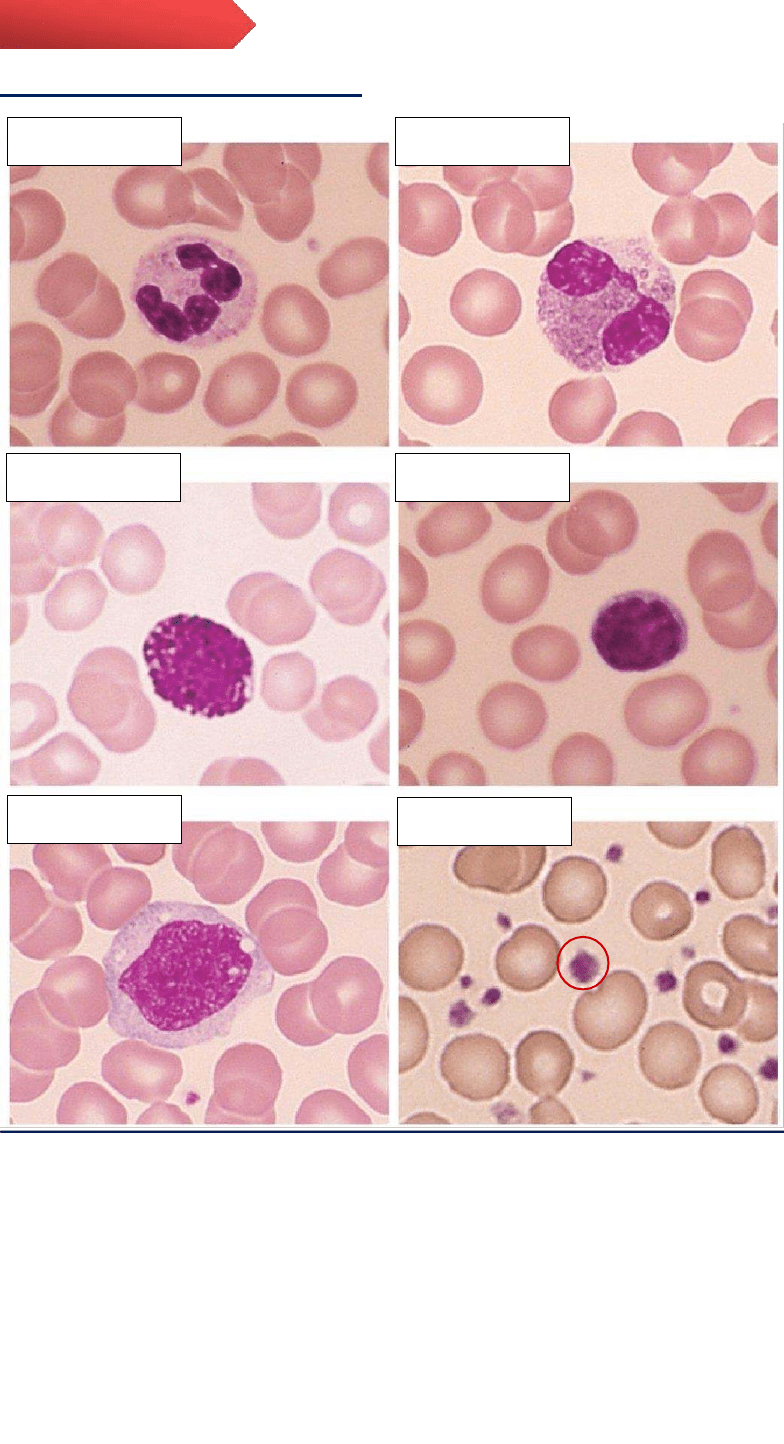

lOMoARcPSD| 21025367
Descargado por Narella Falcone (nfalcone@filadd.com)
UNIVERSIDAD AUTÓNOMA DE NUEVO LEÓN
INMUNOLOGIA
Unidad de aprendizaje: Inmunología
Nombre del alumno: Britany Paloma Castillo Martínez
Grupo:
262
Facilitador: Dr. Ricardo Alberto Gómez Flores

lOMoARcPSD| 21025367
Descargado por Narella Falcone (nfalcone@filadd.com)
Los leucocitos, conocidos también como glóbulos blancos, son un
componente importante de la sangre y una pieza clave en el sistema
inmunológico del cuerpo. Existen cinco tipos diferentes de leucocitos
(neutrófilos, basófilos, eosinófilos, monocitos y linfocitos), cada uno con
funciones específicas y se pueden dividir en dos tipos principales: los
granulocitos (neutrófilos, basófilos, eosinófilos) y agranulocitos (monocitos
y linfocitos).
El recuento diferencial de leucocitos consiste en determinar la cantidad
(porcentaje) de cada tipo de célula blanca presente en la sangre. Dicho
recuento requiere de la realización de un frotis sanguíneo para
posteriormente ser teñido con la tinción de Wright, esto con la finalidad de
facilitar la diferenciación de las células. Finalmente se realizará el conteo
bajo el microscopio, utilizando aceite de inmersión y un aumento de 100x.
La importancia del recuento de leucocitos radica en que se pueden observar
leucocitos inmaduros, maduros o atípicos, si presentan vacuolizaciones,
granulaciones toxicas y si su numero corresponde al adecuado, ayudando al
diagnóstico de afecciones como: infecciones, alergias, reacciones
inflamatorias, etc.
Determinar e identificar la presencia de los distintos leucocitos presentes
en una muestra de sangre.
INTRODUCCIÓN
OBJETIVO

lOMoARcPSD| 21025367
Descargado por Narella Falcone (nfalcone@filadd.com)
Frotis sanguíneo
Materiales:
Muestra de sangre y dos portaobjetos.
Procedimiento:
1.
Colocar una gota de sangre en el
portaobjetos (soporte), a 1.5 cm
de la orilla, procurando dejarla en
el centro.
2.
Con el otro portaobjetos algo
inclinado, se toca lo gota,
haciendo que se expanda a lo
ancho de este, dibujando una línea
de sangre.
3.
Una vez expandida la sangre a lo
ancho del portaobjetos, se desliza,
procurando no hacer pausas para
evitar estrías, al igual que
cuidando el grosor de la lámina.
Cola
Cuerpo
Cabeza
4.
Detener el extendido de tal manera que la cola quede delicadamente
deshilachada (semejando barbas) y con un margen adecuado.
5.
Dejar secar.
6.
Rotular el frotis con el nombre del paciente.
METODOLOGÍA

lOMoARcPSD| 21025367
Descargado por Narella Falcone (nfalcone@filadd.com)
*El frotis ideal es aquel que no abarca ni muy poco, ni demasiado espacio
del portaobjetos, al igual que no debe ser ni muy fino ni muy espeso.
Tinción de Wright
Composición: azul de metileno en un 50-75% y eosina, disueltos en metanol
(permite fijación de células). En los leucocitos tiñe el núcleo de color púrpura
y el citoplasma ligeramente azulado.
Materiales:
Frotis sanguíneo.
Puente de tinción.
Colorante de Wright.
Solución buffer pH 7,2.
Piseta.
Procedimiento:
Cristalizador o vertedero.
Pipeta Pasteur.
Tubo de ensayo.
Cubre objetos.
1.
Se coloca el puente de tinción en el cristalizador o en un vertedero con
el frotis encima.
2.
Se cubre de colorante Wright utilizando una pipeta Pasteur. Esperar un
minuto, escurrir y
3.
enjuagar con solución buffer.
4.
Dejar secar verticalmente.
5.
Mezclar en un tubo de ensayo 0.5 ml de Wright y 0.5 ml de solución
buffer.
6.
Aplicar en la muestra y deja actuar de 3 a 5 minutos.
7.
Escurrir exceso de colorante y enjuagar con agua destilada.
8.
Lavar de nuevo con solución buffer.
9.
Escurrir y dejar secar verticalmente de nuevo.
10.Finalmente, colocar cubre objetos una vez haya secado.

lOMoARcPSD| 21025367
Descargado por Narella Falcone (nfalcone@filadd.com)
Conteo diferencial (microscopio)
Material: Resultados obtenidos del frotis.
Procedimiento:
1.
Colocar frotis sanguíneo sobre la platina del microscopio y enfocar
directamente con el objetivo de 100x (inmersión).
2.
Contar 100 leucocitos y registrar el número correspondiente de neutrófilos,
basófilos, eosinófilos, linfocitos y monocitos.
3.
Para obtener las cifras absolutas, transformar la cifra porcentual de cada
tipo de leucocito, tomando como número total de estos al cien.
*Se pueden contar desde 100, 200 hasta 500 células, entre mayor sea el
número el resultado será más preciso, pero generalmente sólo se manejan
entre 100 y 200.
lOMoARcPSD| 21025367
Descargado por Narella Falcone (nfalcone@filadd.com)
Células observadas en el frotis:
RESULTADOS
Plaquetas
Monocitos
Linfocitos
Basófilos
Eosinófilos
Neutrófilos

lOMoARcPSD| 21025367
Descargado por Narella Falcone (nfalcone@filadd.com)
Conteo diferencial:
LEUCOCITO
CANTIDAD
%
VALOR DE REFERENCIA
Neutrófilos
57
57%
60-70%
Eosinófilos
2
2%
2
-
4
%
Basófilos
1
1%
0.5-1%
Monocitos
3
3%
3
-
8
%
Linfocitos
37
37%
20-25%
TOTAL
100
100%
100%
*La mayoría de los leucocitos se encuentran dentro de los valores de
referencia a excepción de los neutrófilos que están ligeramente disminuidos
respecto a su porcentaje y los linfocitos que se encuentran elevados respecto
al valor de referencia.
El recuento diferencial de leucocitos es un método tradicional basado en una
preparación a partir de una extensión sanguínea que se realiza mediante
microscopia óptica a partir de un frotis teñido que sirve para evaluar la
morfología de eritrocitos y trombocitos y la generación del recuento
diferencial de leucocitos para el diagnóstico de enfermedades hematológicas
(Castillo, 1995).
En este trabajo se observó un frotis de sangre teñido por medio de una tinción
de Wright desarrollada por el patólogo James H. Wright en 1902, utilizada
para diferenciar elementos formes de la sangre. (López-Jácome, 2013). El
recuento diferencial de leucocitos corresponde a la concentración de
subpoblaciones de glóbulos blancos en sangre periférica donde se pueden
diferenciar 5 poblaciones como lo son neutrófilos, eosinófilos, basófilos,
linfocitos y monocitos (Campusano, 2007). Mediante la observación
microscópica se pudieron observar valores que se encuentran dentro del
DISCUSIÓN

lOMoARcPSD| 21025367
Descargado por Narella Falcone (nfalcone@filadd.com)
rango de referencia en la cuenta de 100 células; eosinófilos, basófilos y
monocitos dentro de los valores normales. Por su parte se pudieron identificar
57 neutrófilos, valor ligeramente menor dentro de los valores de referencia
utilizados en esta práctica, esto pudiera no ser significativo ya que hay
laboratorios que manejan los valores de referencia a partir de 40%. Fueron 37
los linfocitos identificados, siendo valores más altos dentro de los valores de
referencia correspondientes a una neutrofilia, el cual es el término empleado
para indicar un valor más alto al esperado en la cuenta de neutrófilos y puede
indicar estímulos como el estrés por ejercicio, infecciones bacterianas o
inflamación. (Campusano, 2008). Debido a que las causas de las alteraciones
sanguíneas pueden ser múltiples es preferible consultar con un especialista
en hematología, además de revisar el historial clínico del paciente sumado a
diferentes estudios para verificar lo que produce las alteraciones.
El recuento diferencial de leucocitos es una técnica muy sencilla y útil
para detectar alteraciones en el porcentaje de células sanguíneas.
Los valores de referencia en el recuento de leucocitos dependerán del
laboratorio donde fue realizado el estudio.
Pequeñas variaciones en el recuento de leucocitos no representan un
problema, pero variaciones evidentes no deben pasarse por alto puesto
que se puede tratar de problemas en la salud de las personas.
CONCLUSIÓN

lOMoARcPSD| 21025367
Descargado por Narella Falcone ([email protected])
Campusano, G. (2007) Del hemograma manual al hemograma de cuarta
generación. Módulo 1 (La clínica y el laboratorio), número 65. Editora Médica
Colombiana S.A., 2007©.Medicina & Laboratorio 2007; 13: 511-550.
Consultado el 3 de octubre de 2021. Disponible en:
https://www.medigraphic.com/pdfs/medlab/myl-2007/myl011-12b.pdf
Campusano, G. (2008) Utilidad del extendido de sangre periférica: los
leucocitos. Medicina & Laboratorio: Programa de Educación Médica Contínua
Certificada Universidad de Antioquia, Edimeco.Volumen 14, Números 9-10,
2008. Consultado el 3 de octubre de 2021. Disponible en:
https://www.medigraphic.com/pdfs/medlab/myl-2008/myl089-10b.pdf
Castillo de Sánchez ML, Fonseca Yerena ME, eds. Mejoría continua de la
calidad: guía para los laboratorios clínicos de América Latina. México:
Panamericana, 1995. Consulado el 3 de octubre de 2021. Disponible en:
https://www.medigraphic.com/pdfs/patol/pt-2013/pt133d.pdf
López-Jácome, L. et al. (2013) Las tinciones básicas en el laboratorio de
microbiología. Laboratorio de Infectología, Centro Nacional de Investigación
y Atención a Quemados (CENIAQ). Investigación en Discapacidad. Vol. 3.
Núm. 1. Enero-marzo, 2014, pp 10-18. Consultado el 3 de octubre de 2021.
Disponible en:
https://www.medigraphic.com/pdfs/invdis/ir-
2014/ir141b.pdf
BIBLIOGRAFÍA

UANL -Inmunologia Práctica acerca del recuento diferencial de leucocitos.pdf
 Estamos procesando este archivo...
Estamos procesando este archivo...
 Lamentablemente la previsualización de este archivo no está disponible. De todas maneras puedes descargarlo y ver si te es útil.
Lamentablemente la previsualización de este archivo no está disponible. De todas maneras puedes descargarlo y ver si te es útil.
Descargar
 Estamos procesando este archivo...
Estamos procesando este archivo...
 Lamentablemente la previsualización de este archivo no está disponible. De todas maneras puedes descargarlo y ver si te es útil.
Lamentablemente la previsualización de este archivo no está disponible. De todas maneras puedes descargarlo y ver si te es útil.